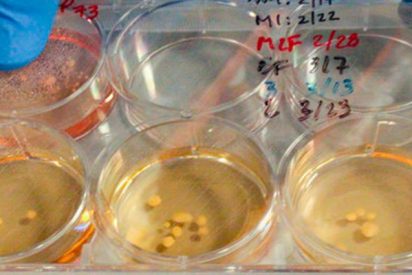

El 40% de las mujeres sufre hipodeseo o trastorno de interés
Médicos de familia han avisado durante las II Jornadas de la Sociedad Española de Médicos de Atención Primaria (Semergen) La Rioja de que el 40 por ciento de las mujeres sufre hipodeseo o trastorno de interés y que, sin embargo, estos problemas no suelen ser comentados en sus consultas. "A nuestras consultas acuden pocas mujeres refiriendo este problema dado el 'tabú'
Los médicos de Atención Primaria avisan de que el 40% de las mujeres sufre hipodeseo o trastorno de interés
Médicos de familia han avisado durante las II Jornadas de la Sociedad Española de Médicos de Atención Primaria (Semergen) La Rioja de que el 40 por ciento de las mujeres sufre hipodeseo o trastorno de interés y que, sin embargo, estos problemas no suelen ser comentados en sus consultas. "A nuestras consultas acuden pocas mujeres refiriendo este problema dado el 'tabú' que suponen la mayoría
Así son los 3 proyectos de los Premios Concordia-Fedefarma de la Facultad de Farmacia y Ciencias de la Alimentación de Barcelona
La Facultad de Farmacia y Ciencias de la Alimentación de Barcelona ha otorgado hoy los premios Concordia - Fedefarma en su cuarta edición, iniciativa que cuenta con la colaboración de la cooperativa. A Al acto de entrega han asistido la directora de la Sección Científica de fedefefarma, Elisenda Casals, y la responsable de Servicios Profesionales y Formación,
Premio ‘Joven Investigador 2018’ y XVI Premios de Investigación para Alumnos de Doctorado
La Real Sociedad Española de Química (RSEQ) y el Comité Europeo para las Relaciones Académicas de Lilly (EUACC, por sus siglas en inglés) han hecho entrega del Premio 'Joven Investigador 2018' y los Premios de Investigación para Alumnos de Doctorado. Así lo han hecho durante la XXVII Reunión Bienal del Grupo de Química Orgánica de
La inhibición de 11 genes podría bloquear más del 99,5 por ciento de las metástasis cancerosas
La inhibición de once genes podría bloquear más del 99,5 por ciento de las metástasis cancerosas, según han descubierto investigadores de la Universidad de Alberta (Canadá) cuyo trabajo ha sido publicado en la revista 'Nature Communications'. En el trabajo, los científicos crearon un embrión aviar sin cáscara para visualizar el crecimiento
Así es el nuevo ecógrafo de Siemens Healthineers que capta imágenes en alta resolución adaptadas al tamaño del paciente
Siemens Healthineers ha presentado el ecógrafo 'Acuson Sequoia', su última innovación en este campo desarrollada para dar respuesta a "uno de los desafíos más prevalentes": lograr imágenes consistentes y claras con independencia de la masa corporal del paciente. Este nuevo ecógrafo, conseguido gracias al desarrollo de su sistema Deep Abdominal Transducer
Comer activa un mecanismo que acelera el metabolismo
Investigadores del Centro de Tomografía por Emisión de Protones (PET) Turku, en Finlandia, han demostrado que comer activa el consumo de oxígeno del tejido adiposo marrón humano (BAT, por sus siglas en inglés), también conocido como grasa parda, tanto como el frío, lo que podría ser útil para regular y acelerar el metabolismo y, así,
¿Sabías que las ‘pepitas rojas’ han resultado ser oro galáctico para los astrónomos?
La naturaleza de una peculiar población de galaxias pequeñas pero masivas llamadas 'pepitas rojas', descubierta hace una década, está determinada por sus agujeros negros. Un nuevo estudio que utiliza el Observatorio de rayos X Chandra de la NASA indica que los agujeros negros han aplastado la formación de estrellas en estas galaxias y que pueden haber usado parte
Descubren que los islamistas jóvenes radicalizados no suelen mostrar patrones específicos de enfermedad mental
Los islamistas jóvenes radicalizados no suelen mostrar patrones específicos de enfermedad mental, según ha puesto de manifiesto un estudio llevado a cabo por expertos del servicio de Psiquiatría de la Infancia y del Adolescente del Hospital Pitié-Salpêtrière de París (Francia) y que ha sido publicado en el 'European Psychiatry'. En comparación
El ‘pisacharcos’ Jaime Peñafiel sube el tono contra la Casa Real con un despiadado ataque contra Felipe VI
Jaime Peñafiel es como un martillo pilón. Cuando pilla una perra con un tema, no suelta hasta despedazarlo o acabar cansado del mismo. El que fuera un egregio cronista de la Casa Real se ha convertido poco menos que en un perseguidor de cualquier desliz, por pequeño que sea, de la reina Letizia y, en menor medida, de los reyes émeritos, principalmente Don Juan Carlos de
¿Sabes cuáles son los cinco mejores dispositivos para convertirse en cyborg?
Hemos creado una lista con algunas de las opciones más interesantes para actualizarse de pies a cabeza, desde las que plantean el verdadero biohackeo, o biohacking (ver Editar el ADN desde casa: la moda que podría convertirse en epidemia), hasta las que simplemente ofrecen una tecnología portable interesante, según recoge Rachel Metz en technologyreview. 1. Nombre:
¿Sabías que los españoles somos de los que más usan Tinder en Rusia durante el Mundial?
Además de las patadas en la cancha, hay algo más que está que arde en el Mundial 2018. Se trata del Tinder de las personas que viajaron a Rusia para apoyar a su equipo en el evento futbolístico más importante, según hipertextual. Desde que comenzó la Copa Mundial de la FIFA hace apenas una semana el pasado jueves 14 de junio, ha habido un aumento del
Cristóbal Soria manda este duro mensaje a Neymar tras lo que sucedió en el Brasil-Costa Rica
El tertuliano de El Chiringuito, Cristóbal Soria, ha compartido un durísimo mensaje en Twitter después de una jugada polémica de Neymar en el Brasil-Costa Rica, según recoge Álvaro Palazón en huffingtonpost En un lance del juego, Neymar ha recibido un leve contacto y se ha tirado al césped. En un primer momento el colegiado ha pitado penalti pero
Los jugadores del Real Madrid arrasan en el Mundial; aunque no todos por igual
Jugadores que SUBEN en este Mundial -Cristiano Ronaldo: El pichichi del torneo va de exhibición en exhibición. Sus cuatro goles lideran a Portugal de cara a meterse en octavos de final. Es el líder de su selección y el jugador al que todos quieren ver, a día de hoy el portugués es el máximo candidato a ser el máximo goleador de un Mundial que
¿Sabías que la clave para perder esa barriga está en la vitamina D?
Un estudio apunta a su utilidad para mantener a raya la grasa del abdomen. Según se reveló en un encuentro de la Sociedad Europea de Endocrinología en Barcelona, las personas con bajos niveles de vitamina D tienden a tener mucha más grasa en el vientre, según computerhoy. La investigación parte de un estudio de Epidemiología
Partidazo en Valladolid
WPT Se enfrentaban dos estilos en la pista central de Valladolid Open. Por un lado la eficacia y la solvencia de la pareja más en forma del momento, Sanyo Gutiérrez y Maxi Sánchez y por el otro el descaro y la intensidad de Lucho Capra y Ramiro Moyano. En el primer capítulo vimos un impresionante despliegue físico de los cuatro jugadores. Ambas
Telecinco se carga ‘Ahora la Mundial’, presentado por Joaquin Prat, tras su fracaso de audiencia
Telecinco quiso 'salvamizar' el fútbol emitiendo el programa 'Ahora la Mundial', pero por ahí no pasan los aficionados al deporte que aglutina masas en todo el mundo. Una cosa es que haya un debate acalorado con expertos y profesionales del balompié, y otra muy diferente que pongan como tertulianos a polemistas colaboradores de programas del corazón para crear confrontación
Lebron James, Ronaldo, Nadal obsesionados con la cámara hiperbárica
La medicina hiperbárica se deja oír últimamente entre los deportistas. Quienes la defienden parecen atribuirle casi una propiedad panacea: quita el dolor, recupera lesiones y hasta mejora el rendimiento deportivo. Al menos eso prometen entrenadores y médicos del mundo de la élite deportiva. ¿Funciona realmente este tipo de tratamiento o es una moda más?
Hospitales de gran reconocimiento y formación completa, claves para elegir Neumología en Madrid
Contar con hospitales de "gran reconocimiento, ofrecer una formación completa al médico residente y tener a sanitarios de amplia trayectoria profesional" son algunas de las razones que hacen de la Comunidad de Madrid una de las "favoritas" para hacer el MIR en Neumología, según Gema María Siesto López, la primera persona en elegir Neumología en la región
La cirugía robótica y la abierta son igual de efectivas en cáncer de vejiga
Un estudio realizado durante siete años en 15 instituciones médicas, entre ellas el Sylvester Comprehensive Cancer Center, de Miami (Estados Unidos), ha concluido que la cirugía robótica y la cirugía abierta tradicional son igualmente efectivas en el tratamiento del cáncer de vejiga. El ensayo de cistectomía abierta aleatorizada versus cistectomía
Identifican los genes asociados a la esquizofrenia en niños
Científicos del Instituto y Hospital Neurológico de Montreal de la Universidad McGill (Canadá) han identificado nuevos genes asociados con una forma específica de esquizofrenia en la infancia, que tiene síntomas similares a los de la forma adulta pero que se manifiesta antes de los 13 años. Los investigadores plantearon este estudio para identificar nuevas
¿Sabías que la terapia a largo plazo con estrógenos altera la composición microbiana y la actividad en el intestino?
La terapia a largo plazo con estrógenos altera la composición microbiana y la actividad en el intestino, tal y como ha mostrado un estudio realizado en ratones por investigadores de la Universidad de Illinois (Estados Unidos) y que ha sido publicado en la revista 'Scientific Reports'. Asimismo, según el trabajo, la enzima B-glucuronidasa (GUS) desempeña un papel fundamental
Descubren cómo funciona el gen antiviral
Investigadores del Colegio de Medicina Albert Einstein de Estados Unidos han descubierto que el gen antiviral RSAD2 codifica una enzima que genera un compuesto que impide la replicación de los virus. El compuesto recientemente descubierto, denominado 'ddhCTP' y publicado en la revista 'Nature', ofrece un enfoque novedoso para atacar muchos virus causantes de enfermedades. "Las modificaciones
El Estadio de San Mamés y la Cibeles se iluminarán de morado este sábado para dar visibilidad al síndrome de Dravet
Edificios y monumentos emblemáticos de España, como la Fuente de la Cibeles (Madrid), el Estadio de San Mamés (Bilbao) o los ayuntamientos de Pamplona, Donostia-San Sebastián o Santiago del Teide (Tenerife), se iluminarán de morado para dar visibilidad al síndrome de Dravet este sábado, Día Internacional de esta patología. Esta enfermedad
Alfonso Ussía deja paralizada a la pizpireta Soraya Sáenz de Santamaría con una salvaje insinuación: «¡Mentirosa!»
Alfonso Ussía se mete este 23 de junio de 2018 de hoz y coz a analizar la carrera electoral que son las primarias en el Partido Popular. En un artículo en La Razón, el genial columnista y escritor deja claras sus preferencias y se decanta por un pacto entre María Dolores de Cospedal y Pablo Casado, al mismo tiempo que pone contra las cuerdas a una Soraya Sáenz de
José Luis Suárez: «El mayor jerarca, el Monarca»
El Fénix de las letras españolas, Lope de Vega, escribió una comedia titulada El mejor Alcalde, el Rey, en la que la Autoridad regia restablece la legalidad del ciudadano Sancho, reponiendo su honor dañado por el noble abusador Don Tello. Si Lope levantara cabeza y observara el momento que vive hoy la ciudadanía española de Cataluña, abusada por los
Este radical experimento hace crecer ‘minicerebros’ de Neandertales para luego hacerlos conducir robots
Entender cómo evolucionó el órgano que nos hace quienes somos es una tarea muy complicada. Y para lograrlo, uno de los pasos a seguir es observar el cerebro de las especies que nos precedieron. Hasta ahora, los investigadores abocados a entender el cerebro neandertal y cómo este difería del nuestro tuvieron que estudiar, literalmente, a un vacío. Lo mejor
Cristianía: Una Mística Monástica para tod@s
(José Antonio Vázquez).- La antigua sabiduría monástica tiene mucho que decir a las mujeres y hombres de hoy. ¿Por qué? Porque el monacato más que una realidad institucional (hoy en día marginal) es una realidad existencial, un arquetipo presente en toda persona. En todo ser humano se da un deseo de unificación o simplificación en
El ataque de la serpiente ‘gigante’ se hace viral pero esconde este secreto
El vídeo, que capta el instante en que una serpiente cae en una trampa al intentar engullir a una 'gallina', ha intimidado a cientos de internautas de la red social. Y es que aunque la secuencia es real, esconde un truco que ha hecho que más de uno se aterrorice por el enorme tamaño del depredador. En principio, las imágenes hacen pensar que la serpiente es una anaconda gigante que se desplaza
Los Simpson predicen la final del Mundial y un evento previo que al parecer ya se cumplió
La popular caricatura anticipó hace más de dos décadas cuáles equipos se verán las caras en una final de este torneo. De acuerdo a lo que ha sucedido, Rusia 2018 podría ser el caso. La popular serie animada Los Simpson, famosa por acertar pronósticos de eventos en el mundo real, predijo que México y Portugal llegarán a una final de la Copa del Mundo. Dicho pronóstico aparece en el episodio
Hay perros policías y también perros ladrones, éste es uno de ellos
Unas cámaras de vigilancia han grabado un robo perpetrado por un inusual grupo de ladrones en Nizhni Nóvgorod (Rusia). En las imágenes se aprecia que los malhechores contaron con la colaboración de un cómplice cuadrúpedo para perpetrar su delito. Así, mientras esos delincuentes vaciaban una tienda local, su perro montaba guardia para avisar ante cualquier
Pánico por un posible ataque armado por parte de un extrabajador de Tesla
Los gerentes de la planta de Tesla en la ciudad de Sparks, en el estado de Nevada (EE.UU.), se encuentran preocupados por un posible ataque armado por parte de un extrabajador de la empresa, informa CNBC. Según ha afirmado al medio el portavoz de la compañía, un amigo de Martin Tripp, trabajador recientemente despedido, llamó a la empresa y aseveró que Tripp
Este objeto no identificado causa un brillante destello en el cielo
Habitantes de cuatro provincias del oeste de Rusia (Vorónezh, Lípetsk, Tula y Oriol) reportaron que en la madrugada de este jueves un objeto celeste no identificado dejó un destello brillante en el cielo. Según las imágenes publicadas en las redes sociales, el objeto surcó rápidamente el cielo causando un destello y dejando una estela blanca
Este tigre ‘ataca’ por la espalda a un visitante en un zoo
Un tigre del zoológico de Baton Rouge, en el estado de Luisiana (EE.UU.), dejó sin aliento a los visitantes del parque cuando inició un sigiloso acercamiento hacia dos turistas que estaban delante de su recinto. Uno de los testigos publicó la grabación en su perfil de Facebook el domingo pasado, y el video que muestra los instintos del feroz depredador rápidamente se volvió viral. El tigre
Melania Trump luce esta polémica chaqueta en su visita a los niños en la frontera
La primera dama de EE.UU., Melania Trump, fue fotografiada este jueves con una chaqueta que ha levantado polémica mientras abordaba el avión que debía llevarla de Maryland a Texas para visitar la frontera entre México y EE.UU., donde actualmente están retenidos hijos de inmigrantes. La controvertida chaqueta llevaba impreso en la
Brasil marca por partida doble y deja fuera a Costa Rica del Mundial
El gol de Coutinho dio aire a la 'canarinha' y Neymar remató el partido para una Brasil necesitada de un triunfo luego del discreto estreno en Rusia 2018 frente a los suizos. Los hinchas brasileños celebran ante la desesperación de los 'ticos' en las gradas del estadio Krestovski de San Petersburgo. Brasil, mediante el gol de Coutinho y el remate de Neymar a un pase de la
Pedro Sánchez suma apoyos para su ‘decretazo’ contra el Consejo de RTVE y se garantiza el ‘incienso’
Pedro Sánchez ha cumplido una de sus prioridades en esta etapa de gobierno: desmantelar el actual equipo directivo y el Consejo de RTVE y así pavimentar el camino para tener a su servicio el ente público y que le de incienso de aquí a las elecciones. El presidente del Gobierno socialista lo ha hecho por decreto y su objetivo ahora es conseguir el apoyo de nuevos partidos
Camión pierde la caja al pasar por debajo de un puente en Australia
Este viernes un camión que circulaba a toda velocidad por una autopista de la ciudad de Melbourne (Australia) protagonizó un aparatoso accidente cuando su caja chocó contra la parte inferior de un puente. Testigos del accidente grabaron un video, compartido luego por el medio local 9NEWS, que muestra el instante exacto de ese choque. La causa de la colisión
El arzobispo de Miami alerta:»Una deportación masiva sería una tragedia para todo el país»
El arzobispo de Miami, Thomas Wenski, y grupos civiles advirtieron hoy que las deportaciones de los inmigrantes que perderán a partir de 2019 el Estatuto de Protección Temporal (TPS) pueden ocasionar otra "tragedia" de separación familiar que afectará a por lo menos 273.000 hijos de inmigrantes. En una rueda de prensa en Miami, Wenski hizo un llamado al Congreso a buscar
Expulsarían del Mundial a estos dos reporteros paraguayos por ofender en guaraní a unos hinchas
Reportan que tanto la FIFA como las autoridades rusas están analizando el comportamiento de los periodistas, que cubren el Mundial para el canal Telefuturo. Dos enviados del canal paraguayo Telefuturo han perpetrado un episodio más de bromas ofensivas como las que ya varios latinoamericanos han repetido en el Mundial de Rusia 2018. Los periodistas Pitu Willis y César
Se incendia en Rusia la turbina de un avión con 70 hinchas peruanos dentro
El vuelo que los transportaba de Ekaterimburgo a Tiumén tuvo que hacer en esa última ciudad un aterrizaje de emergencia tras sufrir la explosión de uno de sus motores. Cerca de 70 aficionados peruanos sufrieron este viernes en Rusia momentos de terror dentro del avión que los transportaba entre las ciudades de Ekaterimburgo y Tiumén, cuando una de sus turbinas
Trump amenaza ahora con un arancel del 20 % para los coches de la UE si no anula sus barreras comerciales
El presidente de Estados Unidos, Donald Trump, ha publicado un mensaje en su cuenta personal de Twitter en el que amenaza con que su país establecerá un impuesto del 20 % a la importación de automóviles producidos en la Unión Europea si ese bloque no elimina "los aranceles y las barreras al comercio" que ha impuesto a compañías y trabajadores estadounidenses.
Decenas de palestinos heridos por soldados israelíes en una protesta en la frontera de Gaza
Docenas de manifestantes palestinos han resultado heridos por las fuerzas israelíes durante una protesta en la frontera de Gaza, según el Ministerio de Salud palestino. Durante la manifestación del viernes fueron registrados 206 casos de lesiones y asfixia por gas, ha reportado el portavoz del Ministerio de Salud en su Twitter. De esas lesiones, 44 fueron heridas de bala, especificó.
El PP financiará la campaña de sus candidatos a presidente y ayudará a los que tengan menos medios
De lo que se trata es de 'alisar' el terreno y que todos compitan en similares condiciones. El PP financiará el grueso de los gastos de campaña de los aspirantes a sustituir a Mariano Rajoy y actuará para evitar que la mayor capacidad financiera de los favoritos impida que el resto tengan las mismas opciones de victoria. Así lo anunció ayer el presidente de la comisión
‘No es abuso, es violación’: Protestas en toda España contra la libertad provisional de ‘La Manada’
La reciente decisión judicial que deja en libertad provisional bajo fianza a los cinco hombres españoles conocidos como La Manada, condenados a nueve años de cárcel por abusar sexualmente de una joven en Pamplona (España) durante las fiestas de San Fermín, ha desatado oleadas de indignación en el seno de la sociedad española. Tras pasar dos años
El Kilauea expulsa violentos chorros de lava desde los 50 metros de altura
En las imágenes aéreas se aprecia como el imponente fujo de roca fundida avanza a velocaidades de hasta 7,7 metros por segundo.
Oscar Ojea advierte: «El nivel de inequidad en Argentina es enorme y se acentúa cada vez más»
(AICA).- El obispo de San Isidro y presidente de la Conferencia Episcopal Argentina (CEA), monseñor Oscar Ojea, advirtió que "el nivel de inequidad es enorme (en el país) y se acentúa cada vez más" y pidió que el ajuste no lo paguen los pobres, al inaugurar la Semana Social en el Hotel Intersur 13 de Julio de Mar del Plata, donde más de 450 dirigentes
Aterrizar es muy complicado
Aterrizar es muy complicado...y este vídeo lo demuestra.
ONU: «En la Venezuela chavista hay ejecuciones extrajudiciales, detenciones y torturas sexuales»
"En la Venezuela chavista hay ejecuciones extrajudiciales, detenciones y torturas sexuales". La ONU denunció este 22 de junio de 2018 la represión del chavismo por las "graves violaciones de los derechos humanos" perpetradas en Venezuela y pidió a la Corte Penal Internacional de La Haya "mayor implicación" ante la deriva del régimen del tirano Nicolás Maduro.
Valbuena del Duero, sinónimo de ‘Eminancia’ enoturística
España, qué duda cabe, es lugar de exquisiteces gastronómicas y enológicas que son la envidia del planeta. La riqueza, sus contrastes y sus paisajes hacen de cualquier rincón de nuestra vasta geografía un referente a la hora de apostar por ese turismo que no sólo busca la playa, sol o montaña. Nuestros visitantes o quienes decidimos pasar nuestro
El corto que lo peta en Facebook
El corto que lo peta en Facebook...ya verás el motivo.
Un perro con mucha suerte y una serpiente con mucha mala leche
Un perro con mucha suerte y una serpiente con mucha mala leche...si no lo ves no lo crees. Estos reptiles no tienen párpados, orejas ni mueven sus ojos. Por eso, para escuchar sienten las vibraciones a través del suelo. Las serpientes mudan su piel al completo casi tres veces al año, en un proceso conocido como ecdisis o muda. Durante la muda, dejan de comer e incluso se vuelven apáticas. CURIOSIDADES
El leopardo intenta ayudar al águila atacada por la serpiente y pasa esto…
Este leopardo intenta ayudar a un águila del ataque de una serpiente y pasa esto…¿quién ganará la partida?. El leopardo es un elegante y fuerte felino emparentado con los leones, los tigres y los jaguares. Tienen manchas en su pelaje, conocidas como "rosetas", que les proporcionan camuflaje en su hábitat natural, que generalmente es boscoso o arbustivo. Estas manchas les permiten mezclarse con
PP y Ciudadanos ‘lloran’ angustiados tras el ‘asalto’ del socialista Sánchez a RTVE
En el pecado llevan la penitencia, al menos y de forma especial los pardillos del PP, que durante siete años tuvieron en los puestos clave de RTVE a personajes sin sustancia, vagos, mangantes y malos periodistas, sólo interesados en salvar el sueldo y el culo ( La última fechoría de Gundín en TVE: rendir culto de personalidad a Pedro Sánchez). Pero las cosas
El más ridículo patinazo de Pedro Sánchez: la historia de ‘Juana la ubicua’
¿Y quién es Juana, si se puede saber? Pues según Pedro Sánchez, que va a terminar haciendo bueno al inefable Zapatero, era una trabajadora con el don de la ubicuidad. Lo mismo estaba en Córdoba, que en Canarias, que en Alicante. Y pluriempleada, porque trabajaba limpiando habitaciones en un hotel de Canarias y en un colegio de Alicante, según le daba al entonces
Adolfo Pérez Esquivel y Daisaku Ikeda llaman a los jóvenes a la resiliencia y a la esperanza
(Adolfo Pérez Esquivel y Daisaku Ikeda, en Redes Cristianas).- Nos dirigimos a los jóvenes del mundo para que se unan y enfrenten los importantes retos de la humanidad, y sean constructores de su propia vida y de la historia del nuevo siglo. Nuestra esperanza es infinita porque estamos convencidos de que sabrán resolver los más diversos imperativos planetarios en unión
In memorian: José Luis Sánchez Nogales (1950-2018)
(Xabier Pikaza).- Ha muerto José Luis, y ha muerto "pronto", todavía "joven", y ahora podrá dialogar con Dios sobre las religiones, y especialmente sobre el Islam, que le tenía atareado. Fuimos durante muchos años colegas, profesores de historia y fenomenología de la religión, él en la Facultad de Teología de Granada, yo en la de Salamanca.
La Sociedad de San Vicente de Paúl entrega su primera medalla “Caridad en Esperanza” al Rotary Club International
(SSVP).- En un acto celebrado dentro del programa de las reuniones de la Estructura Internacional de la SSVP, en el que están representados los 153 países en los que está presente, actuando como anfitriona la SSVP en España representada por su Presidente Nacional D. Juan Manuel Buergo, el Presidente General Internacional D. Renato Lima de Oliveira, en un emotivo acto ha
Franco, ese Hombre…cillo
(Ángel Manuel Sanchez).- «Yo no haré la tontería que hizo Primo de Rivera. Yo no dimito. De aquí al cementerio.» (Francisco Franco Bahamonde). Antes de que pueda darse la grotesca situación en una Democracia de que una versión histórica única y oficial amordace la libre investigación y expresión, se debe juzgar a Franco
Esta mujer fan del béisbol resulta lesionada en pleno partido por una ‘salchicha voladora’
Philadelphia Phillies (Phillies de Filadelfia en español) es un equipo de de béisbol de Grandes Ligas con sede en Filadelfia, Pensilvania. Es uno de los más antiguos de la Liga Nacional, en la que participan desde 1883, desde la realineaciación de esta liga en 1969 forman parte de la División Este de la misma, según wp. Es el equipo con mayor antigüedad
Caballero: «Pedir disculpas ganando y no hablando»
Cometer errores es de lo más habitual y normal, todos los cometemos, pero dependiendo cómo actuemos ante ese error, creceremos y aprenderemos o nos quedaremos estancados. Hay dos maneras de actuar ante un fallo cometido: esconderlo o reconocer los errores para crecer, según lamenteesmaravillosa. “Si no vas a reconocer los errores, no es justo que señales los errores
El adolescente que fue reprimido por Macron está «abatido» y «se ha encerrado en casa»
El presidente de Francia, Emmanuel Macron, reprendió a un joven estudiante que durante un acto conmemorativo le saludó al grito de "¿Qué pasa, Manu?", según cadenaser, y a quien respondió con un "a mí me llamas señor presidente o señor". El adolescente al que el presidente de Francia, Emmanuel Macron, reprendió por haberle llamado
Así será el submarino espía más avanzado de EE.UU.
Hay muchos más submarinos militares que civiles en funcionamiento. Los submarinos son muy útiles desde el punto de vista militar por ser difíciles de detectar y destruir cuando navegan a gran profundidad, según wp. Se presta mucha atención en el diseño de estos submarinos para que al desplazarse lo hagan silenciosamente y eviten su detección: el sonido
Multan al primer ministro de Canadá con 100 dólares por no declarar un par de gafas que le regalaron
Justin Pierre James Trudeau (Ottawa, 25 de diciembre de 1971) es un político liberal canadiense. Tras la victoria por mayoría absoluta del Partido Liberal en las elecciones federales de octubre de 2015, según wp, es el primer ministro de Canadá desde el 4 de noviembre de 2015. Lidera el Partido Liberal desde el 14 de abril de 2013. Desde 2008 es parlamentario por el distrito
Muere Vinnie Paul, uno de los fundadores de Pantera, a los 54 años
Vinnie Paul Abbott (Dallas, 11 de marzo de 1964 - 23 de junio de 2018) fue un músico y compositor estadounidense, más conocido por haber tocado la batería en las bandas de groove metal Pantera y Damageplan, además de haber permanecido en el supergrupo Hellyeah, según wp, siendo el principal miembro fundador. Este viernes 22 de junio de 2018, la banda estadounidense
Le llueven las críticas a Shakira por vender este collar que evoca un símbolo nazi
El sol negro es un antiguo símbolo de los pueblos germánicos, que representaba el día del fin del mundo, según wp, la batalla de los dioses contra los jotuns, y posteriormente ligado a la filosofía ocultista del nazismo. En alemán, Schwarze Sonne también se refiere al término Sonnenrad (en alemán "rueda solar"), símbolo de esoterismo
Despiden a un alto ejecutivo de Netflix por pronunciar una palabra racista en el trabajo
Racismo, según el diccionario de la Real Academia Española, es un sentimiento exacerbado del «sentido racial» de un grupo étnico, según wp, que habitualmente causa discriminación o persecución contra otros grupos étnicos. La palabra designa también la doctrina antropológica o la ideología política basada en ese
Un asesor iraní afirma que EE.UU. sufrirá «otro Vietnam» en Siria
La guerra de Vietnam (Vietnam War en inglés, Chiến tranh Việt Nam en vietnamita) llamada también Segunda Guerra de Indochina o guerra contra los Estados Unidos para los vietnamitas, fue un conflicto bélico librado entre 1955 y 1975 para impedir la reunificación de Vietnam bajo un gobierno socialista o comunista, segñun wp. En esta guerra participó
Kim Dotcom cree que la arrogancia de EE.UU. y las guerras comerciales favorecerán y mucho a las criptomonedas
En los sistemas de criptomonedas, se garantiza la seguridad, integridad y equilibrio de sus estados de cuentas (contabilidad) por medio de un entramado de agentes (transferencia de archivo segmentada o transferencia de archivo multifuente) que se verifican (desconfían) mutuamente llamados mineros, que son, en su mayoría, público en general y protegen activamente la red (el entramado) al mantener
El rapero Akon planea crear una ciudad futurista con su propia criptodivisa
Está previsto que en el futuro la computación cuántica pueda llegar a ser una realidad, lo que rompería el equilibrio en caso de que los desarrolladores no pudieran implementar a tiempo el sistema para usar algoritmos poscuánticos, por tratarse de una tecnología propietaria, según wp. Las criptomonedas hacen posible el llamado internet del valor, también conocido por las siglas IoV (del inglés
¡Alerta sanitaria!: Encuentran en EE.UU. un virus nunca antes detectado en personas
Los virus infectan todos los tipos de organismos, desde animales, hongos, plantas, hasta bacterias y arqueas. También infectan a otros virus; en ese caso reciben el nombre de virófagos. Los virus son demasiado pequeños para poder ser observados con la ayuda de un microscopio óptico, por lo que se dice que son submicroscópicos; aunque existen excepciones entre los
Julia Otero se inventa unas amenazas por La Manada y hunden su imagen
La periodista progre de Onda Cero, Julia Otero, conductora del programa vespertino Julia en la Onda quiere ser más papista que el Papa, más feminista que la mayor de las feministas, la niña en el bautizo o la muerte en el entierro. Su afán de protagonismo crece al tiempo que disminuye su influencia periodística gracias al tremendo sectarismo que está alcanzando
Francisco pide ayudas para África y que se ponga fin a las guerras que la asolan
(Vatican News).- La mañana del sábado 23 de junio el Papa Francisco recibió en audiencia, por primera en el Vaticano, a una delagación de la Organización de Iglesias Instituidas en África, a la cual el Pontífice agradeció "su predisposición para buscar vínculos más estrechos con la Iglesia católica". En su discurso
Receta de pollo al horno al limón y orégano
Una de las recetas de pollo al horno más fáciles, con limón, orégano y romero. ¿Cómo evitar nos quede muy reseco? Cocinar el pollo tiene sus trucos, en otro artículo de Periodista Digital preparamos pechugas de pollo con miel y mostaza, hoy un pollo al horno con limón. Trucos para cocinar el pollo Si quieres una receta con más sabor usa un pollo de corral, si carne es más firme, se alimentan
‘Factor X’ certifica su defunción anotando un solo dígito y siendo la 4ª opción de la noche del viernes
'Factor X', el talent de Telecinco de la noche de los viernes vuelve a dar la razón al refranero español. En esta ocasión hace bueno el refrán "Quien mal empieza mal acaba". El programa de Mediaset España presentado por Jesús Vázquez y que tiene como jurado a Laura Pausini y Risto Mejide, ya dio síntomas de debilidad en sus inicios, según
Cañizares pide a los nuevos sacerdotes privilegiar a los más pobres «porque es la evangelización auténtica»
(Archivalencia).- El cardenal arzobispo de Valencia, Antonio Cañizares, ha conferido hoy la ordenación sacerdotal a diez diáconos valencianos, y les ha pedido "actuar y hablar con valentía y libertad, con fe profunda, alentando siempre la esperanza como testigos del Señor resucitado". En una multitudinaria celebración ante miles de fieles en la Catedral de
El Vaticano condena a cinco años de cárcel a un cura que poseía pornografía infantil
El sacerdote italiano Carlo Alberto Capella, ex diplomático en Washington, intercambió pornografía infantil a través de una red social en un momento de "conflicto interior", según admitió durante el juicio que comenzó el viernes en el Tribunal del Vaticano. El religioso ha sido condenado a cinco años de prisión y 5.000 euros de multa. Capella,
Anabel Pantoja reta a sus ‘haters’ en las redes sociales mostrándoles su «cucu»
A Anabel Pantoja le gusta su cuerpo y eso está muy bien. Le encantan sus curvas y ningún 'troll' o 'hater' va a evitar que las muestre si a ella le gustan. Como siempre recibe numerosos comentarios ofensivos de toda esa pandilla basura que pulula y navega en las redes y que las utilizan para desfogarse, según recoge Exclusiva Digital, la sobrina de Isabel Pantoja, haciendo un símil
El papa nombra a Flores obispo de Villarrica (Paraguay)
El papa Francisco ha nombrado a Adalberto Martínez Flores obispo de la diócesis de Villarrica del Espíritu Santo, en el sur de Paraguay, informó hoy la Santa Sede en un comunicado. Martínez Flores nació en Asunción el 8 de julio de 1951, se licenció en Teología en la Universidad Pontificia Lateranense de Roma y fue ordenado sacerdote el
Obispos de Nicaragua piden a Ortega que acepte elecciones anticipadas
El Episcopado de Nicaragua pidió hoy al presidente Daniel Ortega que acepte "formalmente" la propuesta de adelantar para marzo de 2019 las elecciones generales, a fin de facilitar el diálogo nacional que está en suspenso y que busca una salida a la crisis que deja al menos 212 muertos en dos meses. La Conferencia Episcopal, mediadora del diálogo nacional, solicitó
Bigote Arrocet tira la casa por la ventana comprando un regalo a Mª Teresa Campos en un bazar chino
Desde la edición de 'Supervivientes' del 2017 y la emisión de las últimas entregas del personality show de 'Las Campos', parece que ha perdido interés mediático Edmundo 'Bigote' Arrocet del que no tenemos mucha información sobre a que dedica su tiempo libre. La última 'mairuchitada' que recordamos del humorista chileno fue cuando quiso ir en autobús
La Secretaría para la Comunicación se ha convertido en Dicasterio
Mediante un Rescripto publicado hoy en el periódico de la Santa Sede, L'Osservatore Romano, el Papa Francisco cambia el nombre de la Secretaría para la Comunicación, que pasa a ser el Dicasterio para la Comunicación En la audiencia del pasado mes de febrero, concedida al Sustituto para los Asuntos Generales de la Secretaría de Estado, Monseñor Angelo Becciu,
Pacaya Samiria: La gran aventura en la selva del Amazonas
La Reserva Pacaya Samiria (RNPS) es un área de bosque húmedo tropical inundable, que comprende provincias del departamento de Loreto, tales como: Requena, Alto Amazonas y Ucayali. Su extensión es de 2'080,000 hectáreas, lo cual hace que sea una de las reservas más extensas de la Amazonía Peruana. En 2015 fue designado como el segundo mejor lugar para la vida